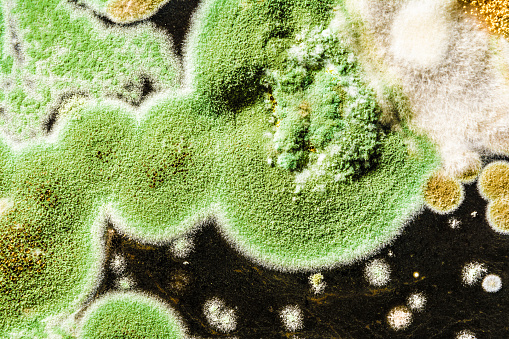

Hóa chất tẩy rửa Trisodium Phosphate TSP
- Trong 1 – 2 Giờ làm việc không bao gồm chủ nhật và ngày lễ
- Đổi trả sản phẩm trong vòng 7 ngày nếu có lỗi từ nhà sản xuất
- Hotline tư vấn 0834.568.987
Tìm hiểu thêm
Trisodium Phosphate (TSP) là hóa chất tẩy rửa mạnh, được sử dụng phổ biến trong xây dựng để làm sạch và chuẩn bị bề mặt trước khi thi công. Với khả năng loại bỏ dầu mỡ, bụi bẩn, và nấm mốc, TSP giúp bề mặt trở nên sạch sẽ, tối ưu hóa độ bám dính của sơn, xi măng hoặc vữa. Nó cũng được dùng để xử lý gỉ sét trên kim loại hoặc làm sạch xi măng, bê tông. TSP tiết kiệm thời gian, chi phí và nâng cao chất lượng công trình. Tuy nhiên, cần sử dụng đúng cách, đeo đồ bảo hộ và rửa sạch bề mặt sau khi dùng để đảm bảo an toàn và hiệu quả.

Thông tin sản phẩm
Tên sản phẩm: Trisodium Phosphate
Tên gọi khác: Natri Phosphat, TSP, Triphosphoric acid, trisodium salt, Sodium phosphate, Phosphate of soda, Na3PO4, Phosphate of soda, Trisodium orthophosphate, Sodium phosphate, Muối photphat natri, Photphat ortho natri, Photphat natri, Muối soda photphat
Công thức: Na3PO4
Số CAS: 7601-54-9
Xuất xứ: Trung Quốc
Quy cách: 25kg/bao
1. Hóa chất tẩy rửa Trisodium Phosphate TSP là gì?
Trisodium Phosphate (TSP) là một hóa chất tẩy rửa mạnh mẽ, được ứng dụng rộng rãi trong ngành xây dựng nhờ khả năng làm sạch hiệu quả và đa năng. TSP thường ở dạng bột hoặc tinh thể màu trắng, tan tốt trong nước và tạo ra dung dịch có tính kiềm cao. Trong xây dựng, TSP chủ yếu được sử dụng để làm sạch và chuẩn bị bề mặt trước khi thi công. Nó loại bỏ hiệu quả dầu mỡ, bụi bẩn, nấm mốc, hoặc các chất cặn bám trên tường, sàn nhà, và kim loại.
Ngoài ra, TSP cũng rất hữu ích trong việc xử lý bề mặt bê tông, xi măng và vữa, giúp cải thiện độ bám dính của các lớp sơn hoặc vật liệu phủ tiếp theo. Trên kim loại, TSP giúp làm sạch dầu mỡ và gỉ sét, chuẩn bị cho quá trình sơn phủ hoặc mạ.
Ưu điểm lớn của TSP là hiệu quả nhanh, tiết kiệm thời gian, chi phí, và giúp nâng cao chất lượng thi công. Tuy nhiên, hóa chất này có tính kiềm mạnh nên cần tuân thủ hướng dẫn sử dụng an toàn. Người dùng nên đeo găng tay, khẩu trang, kính bảo hộ và rửa sạch bề mặt sau khi dùng để đảm bảo an toàn cho người lao động và môi trường.
2. Tính chất vật lý và hóa học của hóa chất tẩy rửa Trisodium Phosphate TSP
Tính chất vật lý
Màu sắc: TSP là một bột hoặc tinh thể màu trắng.
Trạng thái: Thường ở dạng bột khô hoặc tinh thể khi ở trạng thái rắn.
Mùi: Không mùi.
Độ tan: TSP tan rất tốt trong nước, tạo thành dung dịch kiềm mạnh (pH khoảng 12 trong dung dịch 1M).
Khối lượng phân tử: Khoảng 163,94 g/mol (đối với TSP anhydrous).
Điểm nóng chảy: TSP có điểm nóng chảy khoảng 73,4°C khi ở dạng hydrat (dodecahydrate, Na₃PO₄·12H₂O). Dạng anhydrous (không nước) có thể bắt đầu phân hủy ở nhiệt độ cao hơn.
Dẫn điện: Dung dịch TSP trong nước dẫn điện tốt vì nó phân ly hoàn toàn thành ion natri (Na⁺) và phosphate (PO₄³⁻).
Độ pH: Dung dịch của TSP có tính kiềm mạnh, với pH khoảng 12, nên có khả năng ăn mòn khi tiếp xúc với da hoặc vật liệu dễ bị ăn mòn.
Dễ hút ẩm: Dạng hydrat của TSP có thể hấp thụ nước từ không khí và trở nên ẩm ướt nếu không được bảo quản trong điều kiện khô ráo.
Tính chất hóa học
-
Tính kiềm:
TSP có tính kiềm mạnh khi hòa tan trong nước. Dung dịch TSP có pH khoảng 12, giúp nó có khả năng làm sạch và trung hòa axit. Vì tính kiềm cao, TSP có thể phản ứng với các chất có tính axit, tạo ra muối và nước.
-
Phản ứng với axit:
Khi phản ứng với axit, TSP sẽ tạo thành muối tương ứng. Ví dụ, với axit hydrochloric (HCl), phản ứng tạo ra axit photphoric và natri chloride (muối ăn):
Na3PO4+3HCl→H3PO4+3NaCl
-
Phản ứng với kim loại:
TSP có thể phản ứng với một số kim loại như nhôm (Al), giải phóng khí hydro (H₂) trong môi trường kiềm mạnh. Tuy nhiên, vì TSP thường được dùng để làm sạch kim loại, nên phản ứng này không xảy ra trong các ứng dụng bình thường.
-
Khả năng hòa tan các muối:
TSP có khả năng hòa tan nhiều muối khác nhau, bao gồm các muối của kim loại nặng như Ca²⁺ và Fe³⁺. Vì lý do này, TSP thường được dùng trong công nghiệp xử lý nước và làm sạch các bề mặt có chứa cặn khoáng hoặc gỉ sét.
-
Phản ứng tạo kết tủa:
Trong môi trường axit, TSP có thể phản ứng với các muối tạo thành kết tủa. Ví dụ, khi hòa tan TSP trong nước có chứa ion canxi (Ca²⁺), nó có thể tạo thành kết tủa Ca₃(PO₄)₂, được gọi là photphat canxi:
3Na3PO4+3Ca2+→Ca3(PO4)2 (kết tủa)
- Phản ứng với nước:
TSP dễ dàng hòa tan trong nước để tạo thành dung dịch kiềm mạnh, nhưng không phản ứng với nước theo kiểu tạo thành các chất khác. Điều này khiến TSP dễ dàng sử dụng trong các công đoạn tẩy rửa.

3. Ứng dụng của Hóa chất tẩy rửa Trisodium Phosphate TSP do KDCCHEMICAL cung cấp
Ứng dụng
1. Làm sạch bề mặt trước khi sơn
- TSP được sử dụng để làm sạch tường, sàn và các bề mặt khác trước khi thi công lớp sơn mới. Nó giúp loại bỏ dầu mỡ, bụi bẩn, nấm mốc và các tạp chất bám trên bề mặt, giúp lớp sơn bám chặt và bền lâu hơn.
- Đặc biệt hữu ích khi sơn lại các bề mặt đã được sơn trước đó, giúp lớp sơn mới mịn màng và lâu dài hơn.
2. Tẩy rửa xi măng và vữa
- TSP có thể loại bỏ các vết xi măng hoặc vữa thừa trên gạch, sàn hoặc các bề mặt bê tông sau khi thi công. TSP giúp làm sạch các cặn vữa cứng đầu mà các chất tẩy rửa khác khó có thể làm sạch được.
- Nó cũng giúp cải thiện độ bám dính của các lớp phủ mới như gạch hoặc lớp sơn.
3. Xử lý gỉ sét trên kim loại
- Trong xây dựng, TSP được sử dụng để làm sạch các bề mặt kim loại, loại bỏ gỉ sét và bụi bẩn, giúp chuẩn bị bề mặt kim loại trước khi sơn hoặc mạ.
- TSP giúp tạo ra một bề mặt kim loại sạch và có độ bám dính tốt cho các lớp phủ tiếp theo.
4. Chống nấm mốc và tảo
- TSP được sử dụng để loại bỏ nấm mốc và tảo bám trên các bề mặt ngoài trời, như tường, sàn bê tông, hoặc mái nhà. Việc loại bỏ nấm mốc giúp bảo vệ công trình khỏi sự suy giảm chất lượng do sự phát triển của các sinh vật này.
5. Tẩy sạch các vết bẩn cứng đầu trên các vật liệu xây dựng
- TSP có thể được sử dụng để làm sạch các vết bẩn cứng đầu từ các vật liệu như gạch men, gạch đá, sàn bê tông, và các vật liệu khác trong các công trình xây dựng.
6. Làm sạch trước khi lắp đặt gạch và đá
- Trước khi lắp đặt gạch hoặc đá, TSP giúp làm sạch các bề mặt, loại bỏ bụi bẩn và các chất bẩn khác, tạo điều kiện lý tưởng cho việc thi công gạch và đảm bảo độ bám dính tốt giữa các lớp vật liệu.
7. Xử lý các vết bẩn khó tẩy trong nhà xưởng
- Trong các công trình xây dựng lớn hoặc trong nhà xưởng, TSP được sử dụng để làm sạch các vết bẩn khó tẩy trên sàn, tường và thiết bị, giúp duy trì môi trường thi công sạch sẽ và hiệu quả.
Tỉ lệ sử dụng
1. Tẩy rửa bề mặt trước khi sơn
- Tỉ lệ pha chế: Pha 1-2 muỗng canh TSP (khoảng 15-30g) với 1 lít nước ấm.
- Cách sử dụng: Dùng dung dịch này để lau hoặc thoa lên bề mặt cần làm sạch. Để khoảng 10-15 phút để dung dịch thấm và làm sạch, sau đó rửa lại bằng nước sạch.
2. Tẩy vết xi măng hoặc vữa trên gạch, bê tông
- Tỉ lệ pha chế: Pha 1/4 cốc TSP (khoảng 50g) với 1 lít nước ấm.
- Cách sử dụng: Dùng bàn chải cứng hoặc miếng bọt biển thoa dung dịch lên vết xi măng hoặc vữa. Chà xát mạnh và rửa lại bằng nước sạch.
3. Làm sạch nấm mốc và tảo trên tường, mái nhà hoặc bề mặt ngoài trời
- Tỉ lệ pha chế: Pha 1/4 cốc TSP (khoảng 50g) với 3 lít nước.
- Cách sử dụng: Thoa dung dịch lên các khu vực có nấm mốc hoặc tảo. Để dung dịch ngấm trong khoảng 10-15 phút, sau đó lau sạch và rửa lại bằng nước sạch.
4. Tẩy rỉ sét trên bề mặt kim loại
- Tỉ lệ pha chế: Pha 2 muỗng canh TSP (khoảng 30g) với 1 lít nước ấm.
- Cách sử dụng: Dùng bàn chải cứng hoặc vải sạch để thoa dung dịch lên bề mặt kim loại bị gỉ sét. Chà xát cho đến khi gỉ sét được loại bỏ, sau đó rửa lại với nước.
5. Làm sạch sàn, tường, thiết bị công nghiệp
- Tỉ lệ pha chế: Pha 1/4 cốc TSP (khoảng 50g) với 2 lít nước.
- Cách sử dụng: Dùng dung dịch để lau hoặc thoa lên bề mặt sàn, tường hoặc thiết bị bị bẩn. Sau khi làm sạch, rửa lại bằng nước sạch để loại bỏ dư lượng hóa chất.
Ngoài Hóa chất tẩy rửa Trisodium Phosphate TSP thì bạn có thể tham khảo thêm các hóa chất dưới đây
Ngoài Trisodium Phosphate còn sử dụng nhiều hóa chất khác với công dụng làm đông bê tông chậm trong xây dựng. Dưới đây là một số hóa chất phổ biến cùng với công thức hóa học của chúng:
- Sodium Gluconate – Natri Gluconat – C6H11NaO7
Giúp làm chậm quá trình đông cứng bê tông và cải thiện tính lưu động. - Calcium Nitrate – Nitrate Canxi – Ca(NO3)2
Hỗ trợ làm đông bê tông trong điều kiện lạnh, duy trì tốc độ đông cứng. - Citric Acid – Axit Citric – C6H8O7
Điều chỉnh pH, làm chậm quá trình đông cứng bê tông. - Tartaric Acid – Axit Tartaric – C4H6O6
Giảm tốc độ đông cứng bê tông, cải thiện khả năng làm việc. - Lignosulfonate – Lignosulfonat – (C9H10O3S)n
Làm chậm quá trình đông cứng, tăng tính linh hoạt của bê tông. - Retarder
Chậm đông cứng bê tông, tăng thời gian thi công. - Sodium Benzoate – Natri Benzoat – C7H7NaO2
Làm chậm đông cứng bê tông, thường dùng trong môi trường nhiệt độ cao. - Formic Acid – Axit Formic – CH2O2
Làm chậm quá trình đông cứng bê tông, cải thiện độ linh hoạt.

4. Cách bảo quản an toàn và xử lý sự cố khi sử dụng Hóa chất tẩy rửa Trisodium Phosphate TSP
Bảo quản
1. Nơi bảo quản
- Khoảng không gian khô ráo và thoáng mát: TSP cần được bảo quản ở nơi khô ráo, tránh độ ẩm cao, vì dạng hydrat của TSP có thể hút ẩm từ không khí và biến thành dạng ướt.
- Tránh ánh sáng trực tiếp: TSP nên được bảo quản trong hộp kín, tránh ánh sáng trực tiếp và các nguồn nhiệt cao.
- Nhiệt độ bảo quản: TSP nên được bảo quản ở nhiệt độ phòng, không quá nóng hoặc quá lạnh. Nhiệt độ lý tưởng là khoảng 15-25°C.
2. Bao bì bảo vệ
- Đóng gói kín: TSP nên được bảo quản trong bao bì kín để tránh tiếp xúc với không khí và độ ẩm. Hãy chắc chắn rằng bao bì không bị rách hoặc hở.
- Sử dụng vật liệu bảo quản phù hợp: Nên sử dụng bao bì nhựa hoặc các vật liệu bảo vệ khác có khả năng chịu được tính kiềm mạnh của TSP.
3. An toàn khi bảo quản
- Tránh xa tầm tay trẻ em và thú cưng: TSP là một hóa chất mạnh có thể gây hại nếu nuốt phải hoặc tiếp xúc với da và mắt, vì vậy nên để nó ở nơi ngoài tầm với của trẻ em và vật nuôi.
- Bảo quản riêng biệt: TSP không nên được bảo quản cùng với các hóa chất khác, đặc biệt là những chất dễ cháy, axit mạnh hoặc các chất không tương thích.
4. Lưu ý khi sử dụng lâu dài
- Kiểm tra bao bì: Trước khi sử dụng lại, hãy kiểm tra bao bì xem có dấu hiệu bị hư hỏng hoặc rò rỉ không.
- Không sử dụng nếu bị ẩm: Nếu TSP đã bị ẩm ướt hoặc có dấu hiệu của sự phân hủy, hãy thay thế bằng sản phẩm mới.
5. Xử lý khi hết hạn hoặc không sử dụng
- Không xả vào hệ thống thoát nước: TSP không nên xả vào hệ thống thoát nước mà không qua xử lý. Nếu không sử dụng, hãy vứt bỏ TSP theo hướng dẫn của cơ quan bảo vệ môi trường hoặc đơn vị xử lý chất thải.
Xử lý sự cố
1. Tiếp xúc với da và mắt
- Dấu hiệu: Da hoặc mắt bị kích ứng, đỏ, bỏng hoặc ngứa.
- Xử lý:
- Da: Rửa ngay lập tức với nước sạch và xà phòng trong ít nhất 15 phút. Nếu có cảm giác đau hoặc kích ứng kéo dài, tham khảo ý kiến bác sĩ.
- Mắt: Rửa ngay với nước sạch dưới vòi nước chảy liên tục trong ít nhất 15 phút. Nếu triệu chứng không giảm, hãy đến cơ sở y tế ngay lập tức.
2. Hít phải bụi hoặc hơi TSP
- Dấu hiệu: Ho, khó thở, cảm giác ngứa hoặc kích ứng trong mũi và họng.
- Xử lý:
- Di chuyển ngay ra khỏi khu vực có hóa chất.
- Hít thở không khí trong lành.
- Nếu triệu chứng nghiêm trọng hoặc không giảm, đến cơ sở y tế ngay lập tức để được điều trị.
3. Nuốt phải TSP
- Dấu hiệu: Đau bụng, buồn nôn, nôn mửa, cảm giác bỏng trong miệng hoặc họng.
- Xử lý:
- Khẩn cấp: Gọi ngay cấp cứu hoặc đến bệnh viện.
- Không cố gắng nôn trớ trừ khi có chỉ dẫn của bác sĩ.
- Nếu người bị ngộ độc có thể uống được, cho uống một ít nước để làm loãng hóa chất, nhưng chỉ khi có sự cho phép của bác sĩ.
4. Tác động với vật liệu khác
- Dấu hiệu: Phản ứng hóa học với các chất khác, gây bốc khói, cháy hoặc tạo ra khí độc.
- Xử lý:
- Ngừng sử dụng TSP ngay lập tức và loại bỏ các vật liệu không tương thích khỏi khu vực làm việc.
- Đảm bảo không có nguồn nhiệt gần nơi phản ứng.
- Nếu có cháy hoặc khói, sử dụng bình chữa cháy loại phù hợp (CO2 hoặc bột khô) để dập tắt đám cháy.
- Nếu có khí độc, đảm bảo khu vực thoát khí và di chuyển đến khu vực thoáng.
5. Rò rỉ hoặc đổ tràn TSP
- Dấu hiệu: TSP bị đổ ra ngoài bao bì, có thể gây hư hỏng cho các bề mặt hoặc ảnh hưởng đến môi trường.
- Xử lý:
- Bảo vệ: Đeo găng tay, khẩu trang và kính bảo hộ.
- Thu gom: Sử dụng chổi, gậy hoặc vật liệu hút ẩm như cát, vôi để thu gom TSP.
- Rửa sạch: Sau khi thu gom, lau sạch khu vực bị đổ bằng nước sạch.
- Vứt bỏ: Đảm bảo chất thải được thu gom và xử lý theo đúng quy định của địa phương. Không xả TSP vào hệ thống thoát nước hoặc nguồn nước.
6. Bị hư hỏng hoặc tiếp xúc với vật liệu không tương thích
- Dấu hiệu: Vật liệu bị hư hỏng, bề mặt không sạch, hoặc không đạt yêu cầu sau khi sử dụng TSP.
- Xử lý:
- Kiểm tra hướng dẫn: Đảm bảo rằng bạn đã sử dụng TSP đúng cách theo hướng dẫn, đúng tỷ lệ pha chế và bảo quản.
- Kiểm tra bề mặt: Nếu có dấu hiệu hư hỏng (chẳng hạn như ăn mòn kim loại, hư hại bề mặt vật liệu), dừng sử dụng TSP trên các bề mặt này và tham khảo ý kiến chuyên gia.
- Bảo vệ bề mặt: Nếu cần thiết, sử dụng các chất tẩy rửa nhẹ hơn hoặc các biện pháp làm sạch thay thế cho phù hợp.
Bạn có thể tham khảo thêm các loại giấy tờ khác của Hóa chất tẩy rửa Trisodium Phosphate TSP
- SDS (Safety Data Sheet).
- MSDS (Material Safety Data Sheet)
- COA (Certificate of Analysis)
- C/O (Certificate of Origin)
- Các giấy tờ liên quan đến quy định vận chuyển và đóng gói CQ (Certificate of Quality)
- CFS (Certificate of Free Sale)
- TCCN (Tờ Chứng Chứng Nhận)
- Giấy chứng nhận kiểm định và chất lượng của cơ quan kiểm nghiệm (Inspection and Quality Certification)
- Giấy chứng nhận vệ sinh an toàn thực phẩm (Food Safety Certificate)
- Các giấy tờ pháp lý khác: Tùy thuộc vào loại hóa chất và quốc gia đích.

5. Tư vấn về Hóa chất tẩy rửa Trisodium Phosphate TSP cấp độ thực phẩm Hà Nội, Sài Gòn
Quý khách có nhu cầu tư vấn Hóa chất tẩy rửa Trisodium Phosphate TSP cấp độ thực phẩm . Hãy liên hệ ngay số Hotline 0867.883.818. Hoặc truy cập trực tiếp website tongkhohoachatvn.com để được tư vấn và hỗ trợ trực tiếp từ hệ thống các chuyên viên.
Tư vấn Hóa chất tẩy rửa Trisodium Phosphate TSP cấp độ thực phẩm
Giải đáp Hóa chất tẩy rửa Trisodium Phosphate TSP cấp độ thực phẩm qua KDC CHEMICAL. Hỗ trợ cung cấp thông tin về Hóa chất tẩy rửa Trisodium Phosphate TSP cấp độ thực phẩm KDC CHEMICAL.
Hotline: 0867.883.818
Zalo : 0867.883.818
Web: kdcchemical.vn
Mail: kdcchemical@gmail.com
Bước 1: Truy cập website và lựa chọn sản phẩm cần mua để mua hàng
Bước 2: Click và sản phẩm muốn mua, màn hình hiển thị ra pop up với các lựa chọn sau
Nếu bạn muốn tiếp tục mua hàng: Bấm vào phần tiếp tục mua hàng để lựa chọn thêm sản phẩm vào giỏ hàng
Nếu bạn muốn xem giỏ hàng để cập nhật sản phẩm: Bấm vào xem giỏ hàng
Nếu bạn muốn đặt hàng và thanh toán cho sản phẩm này vui lòng bấm vào: Đặt hàng và thanh toán
Bước 3: Lựa chọn thông tin tài khoản thanh toán
Nếu bạn đã có tài khoản vui lòng nhập thông tin tên đăng nhập là email và mật khẩu vào mục đã có tài khoản trên hệ thống
Nếu bạn chưa có tài khoản và muốn đăng ký tài khoản vui lòng điền các thông tin cá nhân để tiếp tục đăng ký tài khoản. Khi có tài khoản bạn sẽ dễ dàng theo dõi được đơn hàng của mình
Nếu bạn muốn mua hàng mà không cần tài khoản vui lòng nhấp chuột vào mục đặt hàng không cần tài khoản
Bước 4: Điền các thông tin của bạn để nhận đơn hàng, lựa chọn hình thức thanh toán và vận chuyển cho đơn hàng của mình
Bước 5: Xem lại thông tin đặt hàng, điền chú thích và gửi đơn hàng
Sau khi nhận được đơn hàng bạn gửi chúng tôi sẽ liên hệ bằng cách gọi điện lại để xác nhận lại đơn hàng và địa chỉ của bạn.
Trân trọng cảm ơn.
Được mua nhiều
Đánh giá (0)
Chưa có bình luận nào






Review Hóa chất tẩy rửa Trisodium Phosphate TSP
Chưa có đánh giá nào.